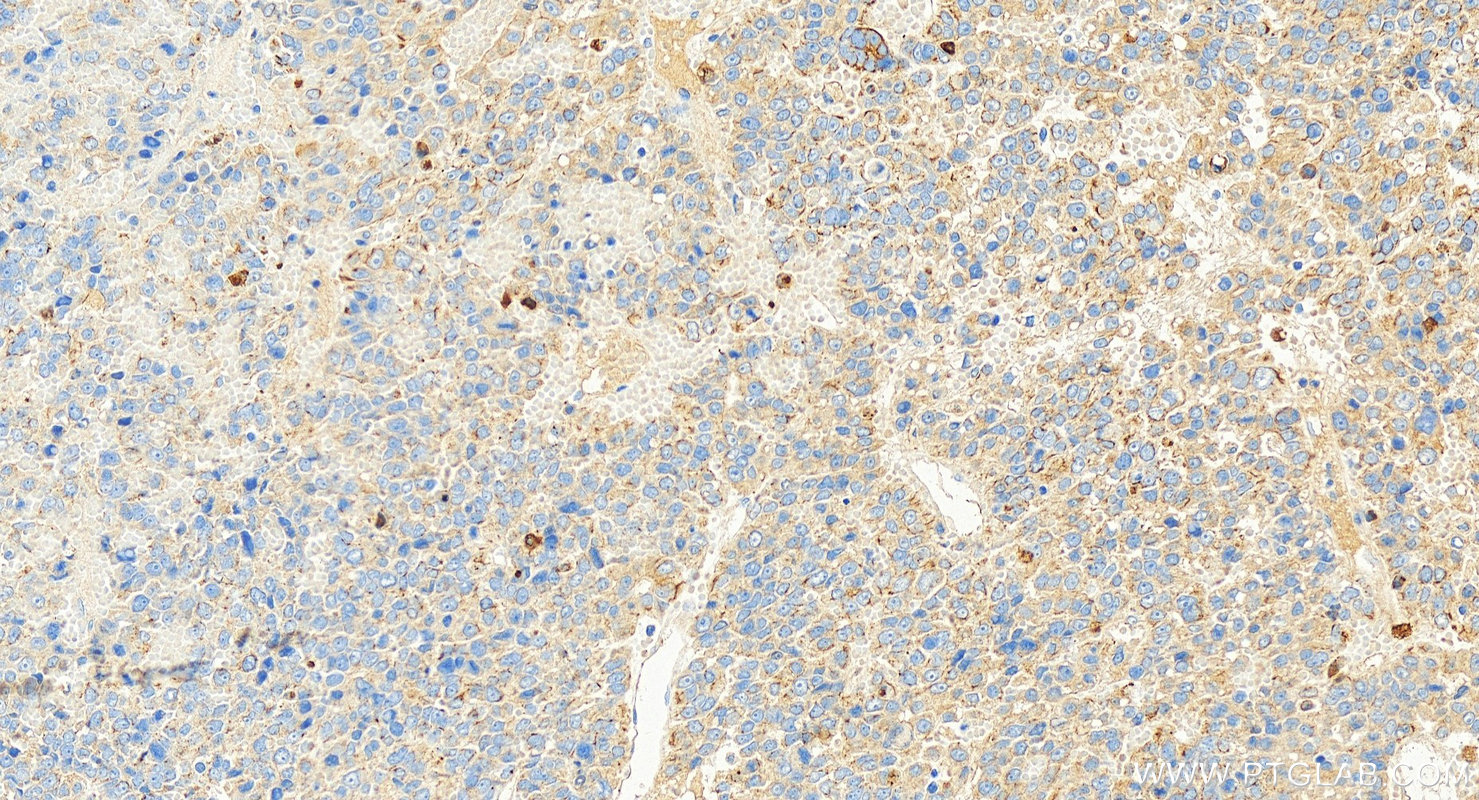

验证数据展示
产品信息
68627-1-PBS targets Cytokeratin 8 as part of a matched antibody pair:
MP51080-1: 68627-1-PBS capture and 68627-2-PBS detection (validated in Cytometric bead array)
Unconjugated mouse monoclonal antibody pair in PBS only (BSA and azide free) storage buffer at a concentration of 1 mg/mL, ready for conjugation.
This conjugation ready format makes antibodies ideal for use in many applications including: ELISAs, multiplex assays requiring matched pairs, mass cytometry, and multiplex imaging applications.Antibody use should be optimized by the end user for each application and assay.
| 经测试应用 | WB, IHC, Cytometric bead array, Indirect ELISA Application Description |
| 经测试反应性 | human, mouse, rat |
| 免疫原 |
CatNo: Ag0488 Product name: Recombinant human KRT8 protein Source: e coli.-derived, PGEX-4T Tag: GST Domain: 1-483 aa of BC000654 Sequence: MSIRVTQKSYKVSTSGPRAFSSRSYTSGPGSRISSSSFSRVGSSNFRGGLGGGYGGASGMGGITAVTVNQSLLSPLVLEVDPNIQAVRTQEKEQIKTLNNKFASFIDKVRFLEQQNKMLETKWSLLQQQKTARSNMDNMFESYINNLRRQLETLGQEKLKLEAELGNMQGLVEDFKNKYEDEINKRTEMENEFVLIKKDVDEAYMNKVELESRLEGLTDEINFLRQLYEEEIRELQSQISDTSVVLSMDNSRSLDMDSIIAEVKAQYEDIANRSRAEAESMYQIKYEELQSLAGKHGDDLRRTKTEISEMNRNISRLQAEIEGLKGQRASLEAAIADAEQRGELAIKDANAKLSELEAALQRAKQDMARQLREYQELMNVKLALDIEIATYRKLLEGEESRLESGMQNMSIHTKTTSGYAGGLSSAYGGLTSPGLSYSLGSSFGSGAGSSSFSRTSSSRAVVVKKIETRDGKLVSESSDVLPK 种属同源性预测 |
| 宿主/亚型 | Mouse / IgG1 |
| 抗体类别 | Monoclonal |
| 产品类型 | Antibody |
| 全称 | keratin 8 |
| 别名 | KRT8, 1F2H5, CARD2, CK 8, CK8 |
| 计算分子量 | 54 kDa |
| 观测分子量 | 50-52 kDa |
| GenBank蛋白编号 | BC000654 |
| 基因名称 | Cytokeratin 8 |
| Gene ID (NCBI) | 3856 |
| 偶联类型 | Unconjugated |
| 形式 | Liquid |
| 纯化方式 | Protein G purification |
| UNIPROT ID | P05787 |
| 储存缓冲液 | PBS only, pH 7.3. |
| 储存条件 | Store at -80°C. The product is shipped with ice packs. Upon receipt, store it immediately at -80°C |
背景介绍
Keratins are a large family of proteins that form the intermediate filament cytoskeleton of epithelial cells, which are classified into two major sequence types. Type I keratins are a group of acidic intermediate filament proteins, including K9-K23, and the hair keratins Ha1-Ha8. Type II keratins are the basic or neutral courterparts to the acidic type I keratins, including K1-K8, and the hair keratins, Hb1-Hb6. KRT8 is often paired with keratin 18 in vivo.